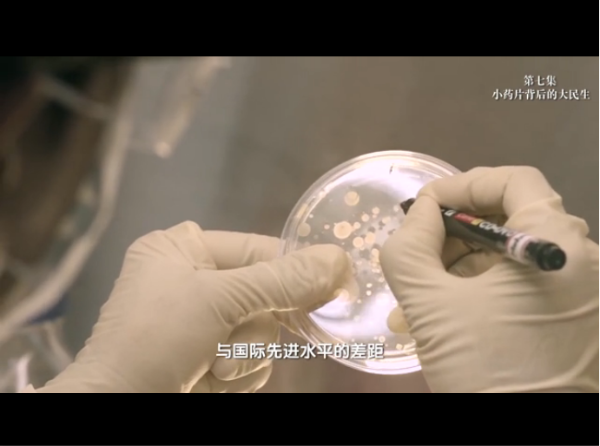
点击查看视频

新华网北京12月19日电 为庆祝改革开放40周年,全面回顾40年来我国卫生健康事业改革发展历程,展示辉煌成就,国家卫生健康委员会组织策划了“致敬伟大改革——对话40年,讲述身边的健康故事”大型访谈节目,由新华网独家首播。
“致敬伟大改革——对话40年,讲述身边的健康故事”本期为第七集——小药片后面的大民生。
在这一集里,北京大学医药管理国际研究中心主任史录文为您介绍如何通过提高药品供应保障能力、改革完善短缺药品供应保障机制,更好地满足人民健康和临床合理用药需求。江苏恒瑞医药股份有限公司董事长孙飘扬与您共同回首民营医药企业改革发展的心路历程,探索小药片后面的大民生。